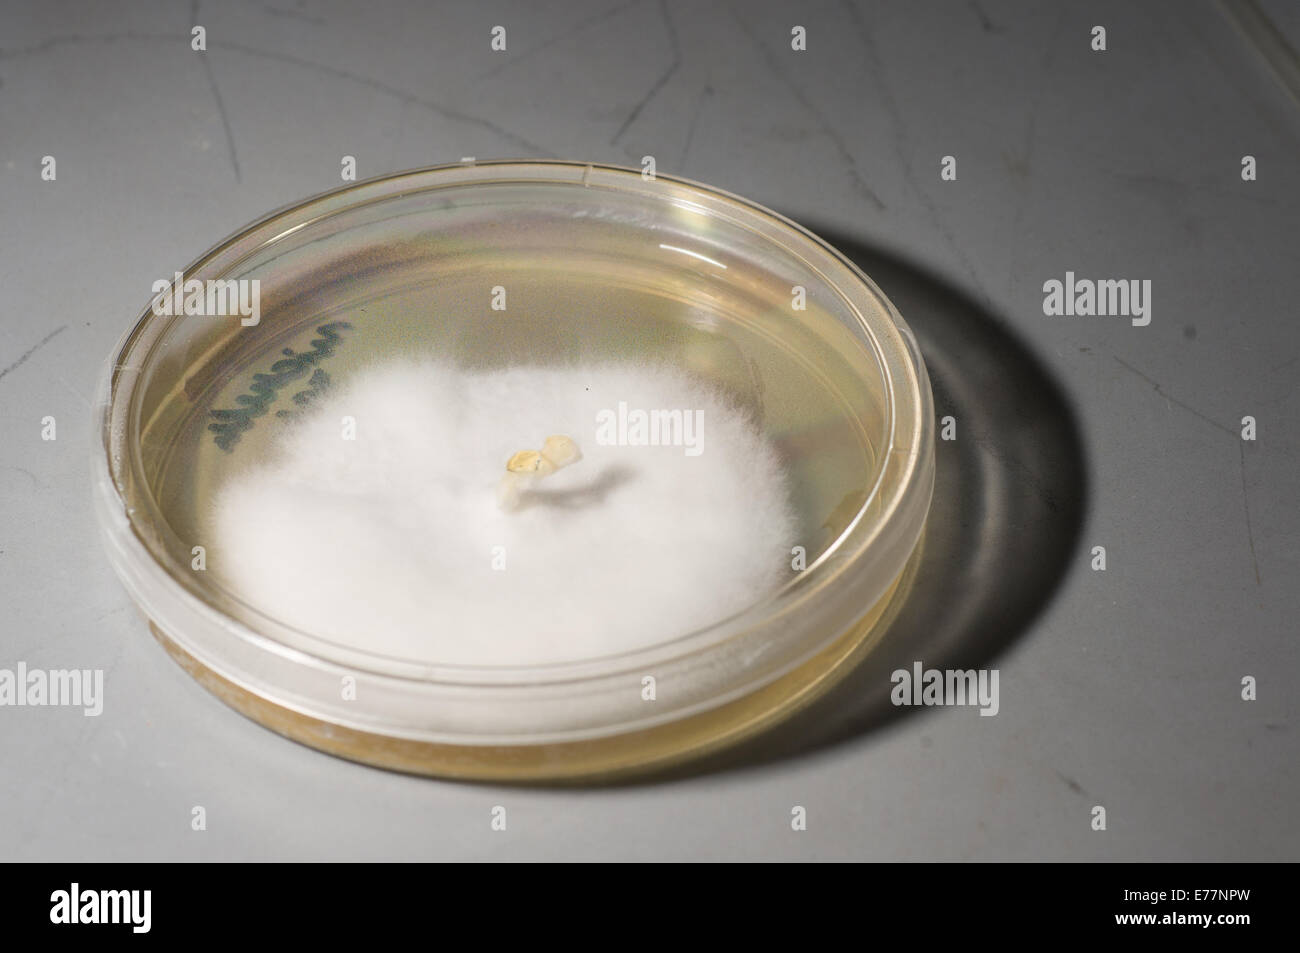

Agar is one of the 230 assembly constituencies of Madhya Pradesh a central Indian state. Agar is a segment of Dewas Lok Sabha constituency.
Members of the Legislative Assembly
^ By-election
Election results
2023
2020 by-election
See also
- Agar Malwa district
- Agar
- List of constituencies of the Madhya Pradesh Legislative Assembly
References